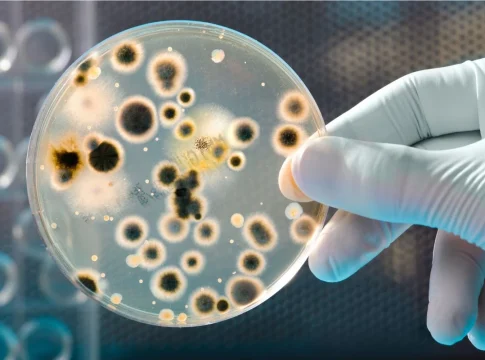

El cortisol puede salvarte o enfermarte, todo depende de cuánto tiempo decidas cargar con él. Claudio Nieto no pretende impresionar con palabras difíciles ni prometer fórmulas milagrosas. Prefiere contar las cosas como son, con la sencillez de quien ha pasado años observando, equivocándose y aprendiendo del cuerpo humano. No todo se resume a contar calorías.
Licenciado en Ciencias de la Actividad Física y el Deporte, profesor de educación física y entrenador personal, Nieto lleva más de dos décadas intentando entender —y hacer entender— cómo funciona el metabolismo. “Me di cuenta de que había muchas lagunas, incluso entre los que trabajábamos en el mundo del deporte”, recuerda. “Así que me puse a estudiar, y un día pensé: ¿por qué no explicarlo mientras aprendo?”
Y ahí está el secreto: su manera de divulgar es, en realidad, una forma de seguir aprendiendo.
El gran malentendido de las calorías

Nieto tiene una cruzada particular contra uno de los mitos más repetidos: que todo se reduce al déficit calórico.
“Si no hay déficit, no hay pérdida de grasa, eso está claro. Pero el problema es cuando convertimos esa consecuencia en la estrategia”, explica.
Habla despacio, con tono de advertencia. “El cuerpo no es una máquina ni una calculadora. Es un organismo complejo, biológico, emocional… humano. Si ves a alguien en redes vendiendo mensajes simples y milagrosos, huye. O no sabe lo que dice o te quiere vender algo.”
“No comemos macros ni calorías: comemos alimentos. El cuerpo entiende de cosas esenciales: grasas, aminoácidos, vitaminas, minerales, fibra, agua… eso es lo que de verdad lo alimenta.”
Cuando el cuerpo se defiende
Según Nieto, la mayoría de las dietas hipocalóricas fracasan, y no por falta de voluntad, sino porque el cuerpo no es tonto. “Si pasas hambre, tu cuerpo lo interpreta como una amenaza. Reduce el metabolismo, ahorra energía, altera las hormonas del hambre… y luego viene el efecto rebote. No es que hayas fallado tú, es que tu cuerpo ha hecho lo que tenía que hacer: protegerte.”
“El cuerpo solo tiene dos órdenes grabadas a fuego: sobrevivir y reproducirse. Cuando siente que una está en peligro, toma el mando.”
Cuando la dieta se convierte en castigo

El discurso se vuelve más serio cuando habla de las mujeres. Su voz baja un poco, casi en tono de respeto.
“Una mujer sin estrógenos es imposible —repito, imposible— que viva bien o tenga calidad de vida desde los treinta y muchos hasta los ochenta y cinco”, dice.
Y no lo dice por exagerar: las dietas demasiado restrictivas pueden alterar el ciclo menstrual, generar cansancio, apatía e incluso una menopausia prematura. “La pérdida de la regla es el aviso más claro de que algo no va bien”, señala. “A veces el cuerpo habla antes de que empiecen los problemas de verdad.”
“La pérdida del ciclo menstrual es un grito silencioso del cuerpo pidiendo equilibrio.”
Estrés, ayuno y sentido común
Nieto también lanza una advertencia sobre el estrés, ese compañero silencioso de la vida moderna. “El cortisol está hecho para salvarte la vida y luego esconderse, no para estar ahí todo el día. Si se queda, destruye músculo, sube la glucosa y acumula grasa.”
“El estrés constante no te empuja hacia adelante: te desgasta poco a poco sin que te des cuenta.”
En cuanto al ayuno intermitente o la dieta cetogénica, los defiende como herramientas útiles, pero con una condición: que se usen con cabeza. “No son ni buenas ni malas, depende del contexto. El problema es querer convertir una herramienta en un estilo de vida eterno.”
Educar el paladar desde la infancia
Cuando el tema pasa a la alimentación infantil, se nota que le toca algo más profundo. “Si educas a un niño a comer dulce todo el tiempo, luego le das brócoli y te mira como si le hubieras dado veneno”, bromea. “Pero no es culpa suya: su cuerpo ya ha aprendido que el azúcar es energía inmediata y lo demás no.”
“Si acostumbramos a los niños al sabor artificial, les robamos la oportunidad de disfrutar de la comida real.”
Por eso insiste en lo básico: comida real, pan bueno (integral, de masa madre, y en su justa medida) y menos ultraprocesados. “El pan blanco industrial puede acompañar, pero no debe ser la base de la dieta.”
Antes de despedirse, deja una frase que resume su filosofía:
“El conocimiento no es poder si no se comprende. Entender cómo funciona tu cuerpo es la base para cuidarlo.”
Puedes contar calorías, pero si olvidas cómo te sientes, las calorías no sirven de nada.